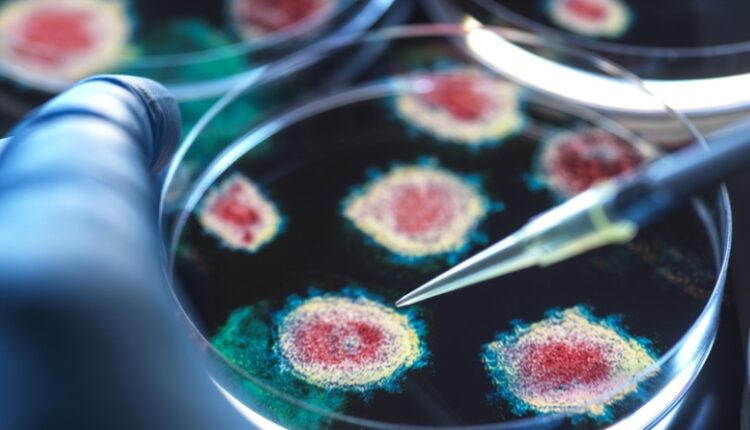

Врач Болибок: последствия «долгого ковида» могут проявляться годами
Врач — иммунолог-аллерголог Владимир Болибок заявил, что наука пока не дала ответа на вопрос, почему возникает так называемый «долгий ковид», когда перенёсшие коронавирус сталкиваются с его последствиями спустя месяцы и даже годы.
Симптомы «долгого ковида» носят мультисистемный характер, затрагивают работу многих органов и систем организма, поделился он в беседе с сайтом kp.ru.
Речь о таких проявлениях, как атипичная усталость, ухудшение памяти или когнитивный сбой, из-за которого человек начинает хуже соображать.
Сложность постковидного состояния ещё и в том, что разные варианты вируса по-разному сочетались с генетическими особенностями каждого отдельного человека, объяснил Болибок. Одни штаммы больше влияли на лёгкие, другие — на нервную систему, третьи — на сосуды.
«Мы научились лечить острую фазу болезни, но для постковида сейчас нет ни единой диагностики, ни единого лечения», — констатировал вирусолог.
Ранее вирусолог, член-корреспондент РАН Александр Лукашев по случаю пятилетия со дня объявления ВОЗ пандемии новой коронавирусной инфекции COVID-19 рассказал, что одним из главных сюрпризов этой пандемии для специалистов стал постковидный синдром.

Комментарии закрыты.